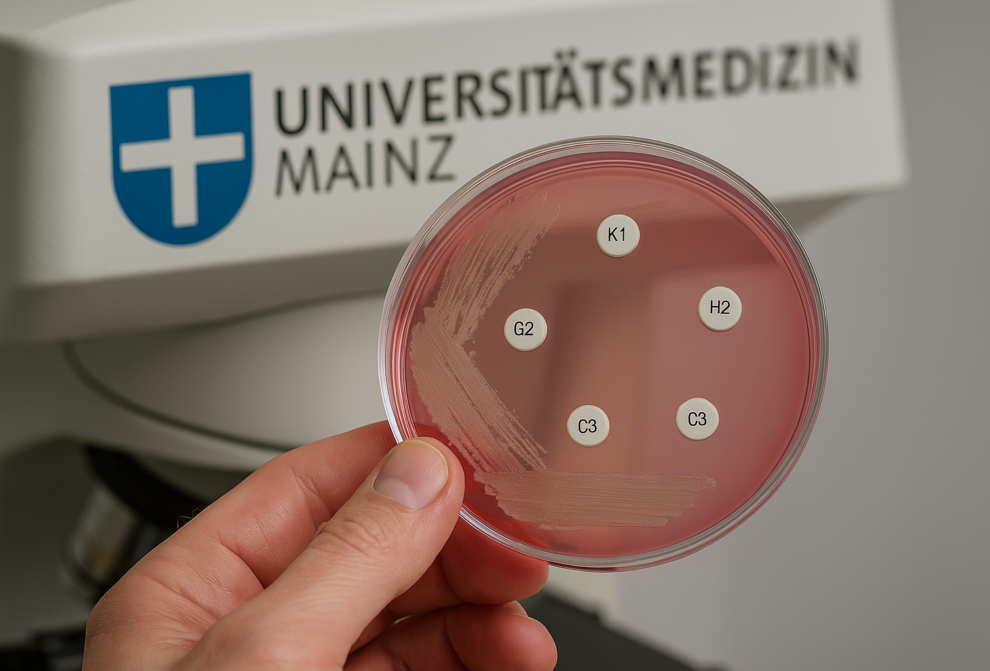
AI Generated Image

Universitätsmedizin Mainz forscht nach Therapie für posttraumatische Schmerzerkrankung
AI Generated Image
Zur Erforschung des komplex-regionalen Schmerzsyndroms (CRPS) erhalten die von Univ.-Prof. Dr. Frank Birklein geleitete Arbeitsgruppe „Schmerz – Autonomes Nervensystem“ der Klinik und Poliklinik für Neurologie der Universitätsmedizin Mainz und das mit ihr kooperierende Forscherteam um die Bioanalytikerin Prof. Dr. rer. nat. Simone König von der Universität Münster rund 460.000 Euro von der Deutschen Forschungsgemeinschaft (DFG).
Das komplex-regionale Schmerzsyndrom ist eine posttraumatische Schmerzerkrankung, die sich bei etwa fünf Prozent der Patienten beispielsweise nach einem Knochenbruch entwickelt. Diese Patienten haben eine gesteigerte Entzündungsreaktion der betroffenen Gliedmaßen, die sich unter anderem in Überwärmung, Ödem, übermäßiger Schweißproduktion und Bewegungsschmerz zeigt. Ziel des dreijährigen, wissenschaftlichen Kooperationsprojektes ist es, die entzündlichen Prozesse im Gewebe zu erforschen, um so eine rasche, gezielte und individuell zugeschnittene Therapie des CRPS zu ermöglichen.
Wenn eine Verletzung, ein Unfall oder eine Operation an Armen oder Beinen schon mehrere Wochen zurückliegt, der Patient aber weiterhin starke und anhaltende Schmerzen gepaart mit vegetativen Symptomen an der betroffenen Extremität hat und sich für diese keine Ursache finden lässt, leidet der Betroffene oft unter dem komplex-regionalen Schmerzsyndrom (CPRS, auch als Morbus Sudeck bekannt). Bei diesem Krankheitsbild klingen die Schmerzen nach einer eher kleineren Verletzung (beispielsweise eine Prellung oder ein verstauchtes Sprunggelenk) oder nach einer Operation wider Erwarten nicht ab. Sie werden stattdessen immer stärker und es kommen weitere Krankheitssymptome wie Schwellungen, Temperaturveränderungen der Haut, ein gesteigertes Nagel- und Haarwachstum oder Bewegungs- und Funktionseinschränkungen hinzu. Wurden bei der ursprünglichen Verletzung Nerven geschädigt, handelt es sich um ein komplexes regionales Schmerzsyndrom des Typ II (CRPS II). In Deutschland sind schätzungsweise jährlich rund 5.000 bis10.000 Patienten betroffen, unter ihnen deutlich mehr Frauen als Männer und meist im Alter zwischen 40 bis 60 Jahren.
Wodurch die Krankheit ausgelöst wird, ist noch nicht erforscht. Deshalb ist die Therapie noch recht unspezifisch. Auch erfolgt die Diagnosestellung oftmals erst im Ausschlussverfahren. Ist die Krankheit aber als solche rechtzeitig erkannt, ist sie in der Regel heilbar. Je früher die Therapie beginnt, umso höher sind die Heilungschancen. Behandelt wird die Krankheit heute mit einer multimodalen Therapie, die standardisiert sowohl medikamentöse als auch physio- und psychotherapeutische Behandlungsformen umfasst.
Die Mainzer Wissenschaftler untersuchen im Rahmen des Forschungsprojektes, wie und warum die entzündlichen Prozesse im Gewebe bei CRPS ablaufen, und vor allem, warum sie nicht wie bei einer physiologischen Wundheilung wieder verschwinden. Die Forscher der Arbeitsgruppe Birklein in der Neurologischen Klinik der Universitätsmedizin Mainz haben mit ihren nationalen und auch internationalen Kooperationspartnern weltweit die meisten wissenschaftlichen Artikel zu dem Thema CRPS publiziert und sind in der Beschreibung und dem Nachweis der Entzündung bei CRPS schon wichtige Schritte vorangekommen. „Auch um gezielte individuelle Therapien zu ermöglichen. muss die Frage nach dem „warum“ beantwortet werden, Die dazu nötigen Schritte wollen wir in diesem Forschungsprojekt leisten“, so Prof. Birklein.
Kontakt
Univ.-Prof. Dr. Frank Birklein, Klinik und Poliklinik für Neurologie
Universitätsmedizin der Johannes Gutenberg-Universität Mainz
Telefon 06131 17-3270, Fax 06131 17-5697
E-Mail: frank.birklein@unimedizin-mainz.de,
Homepage: www.unimedizin-mainz.de/neurologie
Pressekontakt
Barbara Reinke, Stabsstelle Kommunikation und Presse Universitätsmedizin Mainz,
Telefon 06131 17-7428, Fax 06131 17-3496, E-Mail: pr@unimedizin-mainz.de
Über die Universitätsmedizin der Johannes Gutenberg-Universität Mainz
Die Universitätsmedizin der Johannes Gutenberg-Universität Mainz ist die einzige Einrichtung dieser Art in Rheinland-Pfalz. Mehr als 60 Kliniken, Institute und Abteilungen gehören zur Universitätsmedizin Mainz. Mit der Krankenversorgung untrennbar verbunden sind Forschung und Lehre. Rund 3.500 Studierende der Medizin und Zahnmedizin werden in Mainz kontinuierlich ausgebildet.









